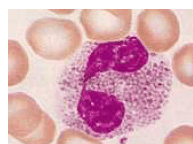
enunciado 1714874-1

Paciente do sexo masculino, de 32 anos de idade, apresentou quadro de diarréia aguda, com sangue e muco em todas as evacuações durante 15 dias, com febre e dor abdominal intensa. Uma ultrassonografia revelou lesão única em lobo direito, compatível com abscesso hepático, o qual foi puncionado para investigação da secreção. Foram solicitados diversos exames laboratoriais, como hemograma, parasitológico de fezes, bacterioscópico e cultura da secreção hepática, diversas dosagens de anticorpos, hemocultura e dosagem de enzimas hepáticas.
Considerando o caso clínico hipotético apresentado, julgue os seguintes itens.
No hemograma de pacientes com parasitoses intestinais, podem-se encontrar os tipos celulares mostrados na figura a seguir.